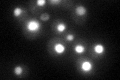
YOR243C
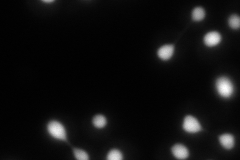
YOR243C
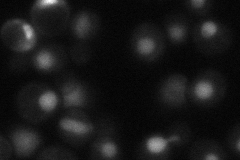
YOR243C
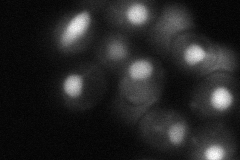
YOR243C

View description
Pseudouridine synthase, catalyzes pseudouridylation at position 35 in U2 snRNA, position 50 in 5S rRNA, position 13 in cytoplasmic tRNAs, and position 35 in pre-tRNA(Tyr); conserved in archaea, vertebrates, and some bacteria
Localization:
Intensity:
Fold change:
Significance:
-
C’ GFP library in SD
nucleus53.36 -
N' NOP1pr-GFP in SD
nucleus127.732 -
N' TEF2pr-mCherry in SD

nucleus165.952 -
N' NATIVEpr-GFP in SD
nucleus40.2814 -
N' TEF2pr-VC and Cyto-VN in SD
nucleus56.9528 -
C’ GFP library in SD+DTT

nucleus36.950.69No -
C’ GFP library in SD+H2O2

nucleus54.351.01No -
C’ GFP library in Starvation Media

nucleus26.340.49Yes -
C’ GFP library on the background of Pup2-DaMP

nucleus -
C’ GFP library on the background of CCT mutant

nucleus54.90471.02874No
